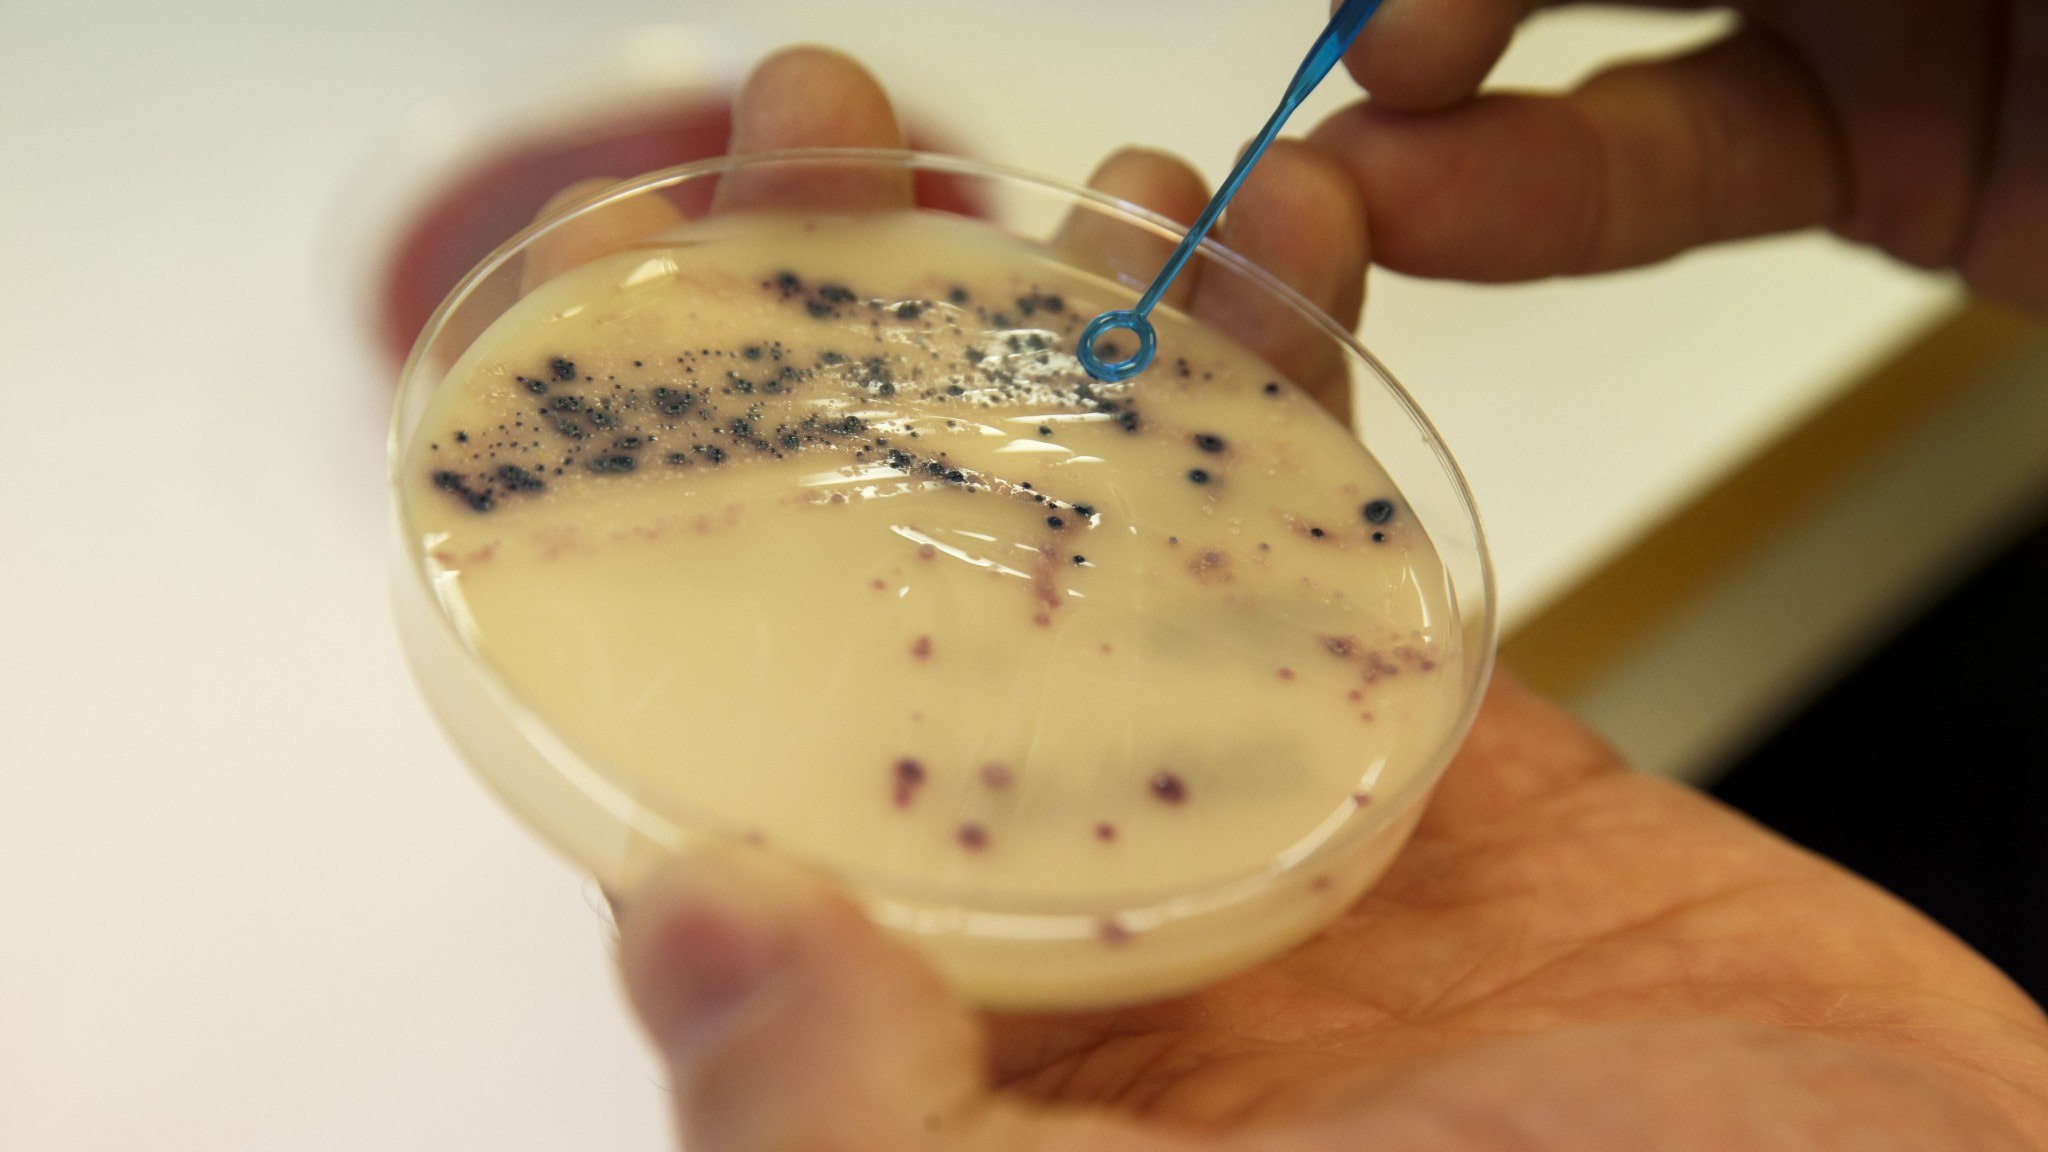
⚡️ کارشناس: فقدان سیستم کارآمد برای توسعه آنتیبیوتیکها
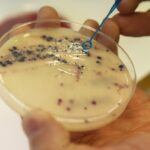

-
⚡️ کارشناس: فقدان سیستم کارآمد برای توسعه آنتیبیوتیکها
✍🏻 مقاومت آنتیبیوتیکی در حال افزایش است و همانطور که اکوت قبلاً گزارش داده است، میتواند به یک مشکل اساسی تبدیل شود، به خصوص برای افرادی که تحت درمان سرطان هستند. اتو…
-

⚡️ پس از افشاگریهای اکوت در مورد معاملات سهام؛ دستورالعملهای جدید برای وزرا
✍🏻 پس از افشاگریهای اکوت در مورد معاملات سهام چندین وزیر، دفاتر دولتی اکنون دستورالعملهای خود را برای سهامداری وزیران تغییر میدهند. طبق دستورالعملهای جدید، که اکوت آنها را مشاهده کرده است،…
-

⚡️ فورسمد در مورد حمایت از مراقبتهای دندانپزشکی: «نباید باعث افزایش قیمتها شود»
✍🏻 حمایت دولتی از دندانپزشکی آنطور که باید عمل نمیکند و باعث افزایش هزینهها هم برای بیماران و هم برای دولت شده است. این را دیوان محاسبات سوئد در گزارش تازهای اعلام…
-

⚡️ یک سوئدی متهم به جاسوسی در ایران زندانی شد
✍🏻 وزارت امور خارجه تایید کرد که یک مرد سوئدی به اتهام جاسوسی در ایران بازداشت شده است. ماریا مالمر استنرگارد، وزیر امور خارجه، در اظهار نظری گفت: «وزارت امور خارجه و…
-

⚡️ بانک بزرگ نرخ بهره وامهای مسکن با سود ثابت را افزایش داد؛ انتظار میرود بانکهای بیشتری از این روند پیروی کنند
✍🏻 نرخ بهره وامهای مسکن با سود ثابت ممکن است بهزودی افزایشی شود. بانک بزرگ نوردیا امروز اعلام کرد که نرخ وامهای مسکن با بهره ثابت خود را بالا میبرد. پیشبینیهای چند…
-

⚡️ گزارش جدید: سوئد ۶ درصد از خریدهای شرکتهای جهانی را به خود اختصاص داده است
✍🏻 بر اساس گزارش جدید Business Sweden، شرکتهای سوئدی تقریباً ۶ درصد از خریدهای شرکتهای فرامرزی جهان را تشکیل میدهند. به گفتهی یان لارسون، مدیرعامل این شرکت، با توجه به سهم اقتصادی…
-

⚡️ اعلام Eon: تعرفههای شبکه برق افزایش مییابد
✍🏻 شرکت E.on نیز تعرفههای شبکه برق را افزایش میدهد. این شرکت که ۱٫۱ میلیون مشترک دارد، روز سهشنبه اعلام کرد که از سال ۲۰۲۶ میانگین هزینههای شبکه برق را حدود پنج…
-

⚡️ صندوق هفتم بازنشستگی دولتی سوئد (AP7) سهام شرکتهای جنجالی را میفروشد
✍🏻 صندوق سرمایهگذاری مشترک سوئد (Seventh AP Fund) تصمیم گرفته است سهام خود را در چند شرکت جنجالی بفروشد. این تصمیم پس از گزارشهای تحقیقی رادیوی اکوت در پاییز گرفته شد که…
-

⚡️ پرنسس سوفیا با جفری اپستین، مجرم جنسی، ملاقات کرده است
✍🏻 بر اساس گزارشها، شاهدخت سوفیا در چند نوبت با جفری اپستین، مجرم محکومشده در پروندههای جرایم جنسی، دیدار داشته است. ماجرا به یک زن تاجر سوئدی مربوط میشود که گفته میشود…
-

⚡️ اوکسون: در مورد همکاری توافق شد اما نحوه آن مشخص نیست
✍🏻 رهبران احزاب موسوم به «احزاب توافق تیدو» روز سهشنبه برای برگزاری یک نشست کاری در اشترنگنس گرد هم آمدند؛ نشستی که در خانه اولف کریسترشون، نخستوزیر سوئد و رهبر حزب میانهرو،…